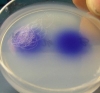
Нематодам поменяли сексуальную ориентацию

отметил
1
человек
в архиве
Держать дом в порядке
Бытовое оборудование сегодня – неотъемлемая часть домашнего уюта и комфорта. Но если «умные» вещи заботятся о нас, то и мы должны ухаживать за ним. Причём внимания от нас требуется совсем немного. Производители домотехники учитывают дефицит времени, буквально преследующий современного человека, и уж...
нет комментариев
проблема (1)
отметили
4
человека
в архиве
У премьер-министра Израиля рак
 lenta.ru
lenta.ru
Премьер-министр Израиля Эхуд Ольмерт заявил 29 октября на пресс-конференции, что врачи обнаружили у него рак простаты, пишет Ha'aretz.
По словам Ольмерта, рак был выявлен во время регулярного медосмотра, проведенного после возвращения премьер-министра из России. Он заявил, что опухоль имеет...
отметили
5
человек
в архиве
В ноябре в Москве начнут выдавать автомобильные номера новой серии - 197
 newsru.com
newsru.com
появление новой серии для номеров постоянно увеличивающимся количеством автомобилей в Москве.
отметил
1
человек
в архиве
КОМПЛЕКСНЫЕ ТЕХНИЧЕСКИЕ РЕШЕНИЯ ДЛЯ ДОМА: ЕДИНСТВО ВРЕМЕНИ И МЕСТА
Что нам стоит дом построить? Учитывая скорость развития строительных технологий, процесс возведения «коробки» сегодня превращается из огромной проблемы в довольно быстроразрешимую задачу. Куда сложнее другой аспект этой темы — снабдить строение необходимыми для современного жилья системами комфорта:...
проблема (2)
отметил
1
человек
в архиве
Rapidshare Premium link generator's downeach.com
Here IS Some Rapidshare Premium link generator's
проблема (2)
отметили
3
человека
в архиве
Фото дня: Фотография “Тайной вечери” разрешением 16 млрд. пикселей
 it-day.ru
it-day.ru
Вы — поклонник творчества Леонардо Да Винчи, а главным шедевром живописи считаете фреску “Тайная вечеря”? Теперь совсем не обязательно приобретать путевку в Милан, чтобы рассмотреть творение великого итальянца в деталях, — в Сети теперь доступна цифровая копия “Тайной вечери” разрешением 16 млрд. пи...
отметили
11
человек
в архиве
На женщину, съевшую протокол ГИБДД, заведено уголовное дело
 gazeta.ru
gazeta.ru
В отношении Натальи Дунаевой, съевшей протокол ГИБДД, возбуждено уголовное дело по статье 325, часть 1 (уничтожение документов) УК России.
отметили
2
человека
в архиве
Судебные приставы закрыли границу для 8,4 тысяч россиян
 gazeta.spb.ru
gazeta.spb.ru
Служба судебных приставов России за 9 месяцев текущего года вынесла постановления об ограничении права на выезд за границу из-за долгов 8 тысячам 366 россиянам, не исполнившим судебные решения.
отметили
4
человека
в архиве
Интервью с создателем игры Blogowar.ru!
В своем блоге я с интересом отношусь к идеям, и их практической реализации. Именно поэтому пообщаться с Дмитрием было для меня очень познавательно. Я надеюсь, что интервью с Дмитрием Смирновым будет интересно любителям блоговойн и многим другим блоггерам!
*Дмитрий, вы являетесь создателем и...
отметили
4
человека
в архиве
Американская и австралийская компании разработали супер-защищенную «кредитку» с кнопками и экраном
 rzn.info
rzn.info
Специальный встроенный чип, 12 кнопок и дисплей, которые инженеры втиснули в габариты стандартной кредитки, позволяют пользователю заранее набрать PIN-код карты. В ответ её владелец получает одноразовый пароль для проведения одного платежа (скажем, в Интернете или через сотовую сеть). При этом исклю...
отметил
1
человек
в архиве
Полисорб МП
 polisorb.ru
polisorb.ru
Детей напоили инфицированным кефиром
Главный врач инфекционного отделения Благодарненской ЦРБ Дмитрий Николаевич Сергеев сообщает, что за помощью обратились 72 человека. Диагноз дизентерия. Причиной возникновения вспышки дизентерии в детских садах Благодарненского района явилось у...
проблема (1)
отметил
1
человек
в архиве
Подольский водоканал взял курс на энергоэффективность
21 сентября 2007 года в рамках проекта масштабной реконструкции подольского Водоканала состоялось открытие обновленного водозаборного узла «Турист». Он оснащен шестью насосами GRUNDFOS. Такое решение уже позволило уменьшить энергопотребление системы на 15%.
Водозаборный узел, который состоит из ...
отметили
66
человек
в архиве
Ученые создали память в 10 раз дешевле флэш
 cnews.ru
cnews.ru
Американские ученые разработали новую память, которая в теории позволит создавать крошечные накопители, вмещающие до 1 ТБ данных. Новая память работает на молекулярном уровне, потребляет намного меньше электроэнергии в сравнении с современными технологиями и недорога в производстве
отметил
1
человек
в архиве
http://пример.испытание - тест новых доменов! Узнайте больше об IDN! idnf.ru
15 октября 2007 года ICANN объявил о начале периода тестирования доменных имён вида пример.испытание (example.test) на 11 языках: русском, арабском, персидском, китайском, хинди, греческом, корейском, идише, японском и тамильском.
На этих доменах пользователи увидят wiki-сайты с указаниями ...
проблема (1)
отметили
37
человек
в архиве
Курс евро по отношению к доллару установил новый рекорд
 top.rbc.ru
top.rbc.ru
Курс евро по отношению к американскому доллару установил очередной рекорд, поднявшись выше отметки 1,4420 долл./евро. Поводом для удешевления доллара на азиатских торгах стало ожидание того, что Федеральная резервная система США (ФРС) сократит процентные ставки на этой неделе и, возможно, еще раз по...
проблема (2)
отметили
43
человека
в архиве
«Битцевского маньяка» приговорили к пожизненному сроку
Так называемый битцевский маньяк Александр Пичушкин получил пожизненный срок отбывания в тюрьме.
отметили
5
человек
в архиве
Последний Гарри Поттер теперь и на китайском
 kitai20.ru
kitai20.ru
28 октября, в воскресенье, в Китае были атакованы книжные магазины Китая — вышла последняя книга о Гарри Потере на китайском языке.
проблема (1)
отметили
11
человек
в архиве
Первые фотографии iPhone Nano
 ru-iphone.com
ru-iphone.com
После выхода Apple iPhone многие с нетерпением стали ждать расширение модельного ряда. Похоже ждать осталось недолго. Вот они первые фотографии Apple iPhone Nano — уменьшейнной копии Apple iPhone. iPhone Nano будет более компактный и менее функциональный.
отметили
3
человека
в архиве
Первые фотографии Sony Ericsson W890 zlaveg.com
Польский ресурс www.se-center.pl разместил первые фотографии телефона Sony Ericsson W890, который еще не был представлен официально. Этот очередной аппарат из музыкальной серии Walkman является наследником Sony Ericsson W880. По сообщению источника, W890 оборудован 2-дюймовым дисплеем с разрешением ...
отметили
4
человека
в архиве
ODF стал государственным стандартом в Южной Африке
 soft.compulenta.ru
soft.compulenta.ru
Открытый формат ODF стал государственным стандартом электронных документов в ЮАР.
Отныне он будет использоваться для всех коммуникаций правительственного уровня.
Внедрение ODF будет происходить в несколько этапов. В начале 2008 года все правительственные учреждения обеспечат конвер...
отметил
1
человек
в архиве
Андрей Малахов благодарил учителей за плохие отметки
 teleweek.ru
teleweek.ru
Популярный телеведущий всегда с благодарностью вспоминает родной город Апатиты, что в Мурманской области. Олег ПЕРАНОВ отправился туда и разузнал, каким Малахов был в детстве.
проблема (2)
отметили
5
человек
в архиве
Нематодам поменяли сексуальную ориентацию
 vokrugsveta.ru
vokrugsveta.ru
Специалисты Института мозга при Университете Юты, США, научились менять сексуальную ориентацию червей-нематод, включая определенные гены. Черви "женского пола" вели себя как мужские особи, реагируя на запах феромонов, выделяемых самками для привлечения особей противоположного пола. Однако ...
отметили
3
человека
в архиве
В Екатеринбурге тестируют IP-телевидение
 dkvartal.ru
dkvartal.ru
В начале 90-х гг. Екатеринбург стал одним из первых городов в стране, где появились частные телекомпании и начали разворачиваться сети кабельного телевидения. К концу 2000-х гг. у столицы Урала вновь есть все шансы стать лидером по применению новых технологий передачи телесигнала как для привычного ...
отметили
7
человек
в архиве
52% японцев в прошлом месяце не прочитали ни одной книги
 news.leit.ru
news.leit.ru
52% японцев в прошлом месяце не прочитали ни одной книги, что по сравнению с прошлым годом больше на 3%. А по сравнению с последними двумя годами, цифра выросла на все 50% — сообщает «Yomiuri Shimbun».
проблема (4)
отметили
2
человека
в архиве
Книги для блоггеров
 ctrlc.ru
ctrlc.ru
Вот дочитав очередную книжку, я пошёл в книжный на новом арбате, что бы прикупить себе очередную книженцию, дабы было что почитать по дороге на работу. Я начал искать книги про блоги и всё что с ними связано, но к сожалению кроме двух книжек, которые у меня уже есть (раз и два) я больше ничего не на...
проблема (1)
отметили
0
человек
в архиве
Монарх Саудовской Аравии впервые за последние 20 лет посетит Великобританию
 britanets.com
britanets.com
Накануне своего официального визита в Лондон король Саудовской Аравии Абдулла обвинил Великобританию в том, что та делает не все от нее зависящее для борьбы с терроризмом, для полной победы над которым может понадобиться от 20 до 30 лет.
проблема (2)
отметили
27
человек
в архиве
Саркози устроил Америке скандал
 dni.ru
dni.ru
Он устроил скандал во время своего интервью телекомпании CBS в программе "60 минут".
Программа, в которой участвовал президент Франции, была направлена на то, чтобы познакомить Америку с Николя Саркози и представить французского лидера с лучшей стороны. Поначалу все получалось име...
проблема (2)
отметил
1
человек
в архиве
Полезные советы по Linux: Планирование задач с помощью cron и at
 ibm.com
ibm.com
Вам требуется запустить задачу в полночь, когда нагрузка на систему минимальна, или есть задачи, которые должны выполняться ежедневно или еженедельно. Другой причиной использовать планировщик задач может быть желание автоматизировать выполнение рутинных задач или стремление обеспечить регулярность и...
проблема (1)
отметили
38
человек
в архиве
Иран угрожает "решительным ударом" в ответ на атаку США
 inopressa.ru
inopressa.ru
Иран выступил с угрозой ответного и "еще более решительного удара", если США подвергнут бомбардировкам его ядерные установки. Поводом к заявлению послужило усиление международной напряженности после ввода Вашингтоном санкций против Тегерана.
отметили
3
человека
в архиве
ICQ, Mail-agent, Opera для мобильника в одном флаконе
 live2hack.info
live2hack.info
Вышла в свет очередная версия Jazzy Midlet 0.4 POPular edition — комплекса программ для общения (ICQ, MRIM, SMS) через мобильный телефон с возможностью отправки бесплатных SMS, а также серфинга по интернету.